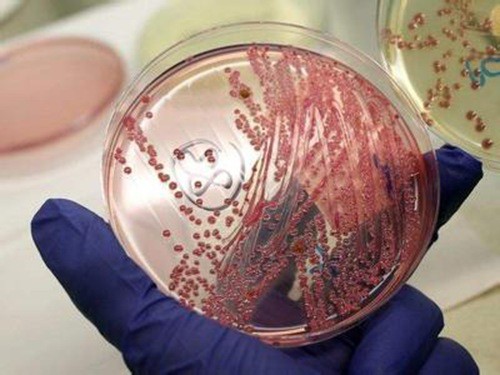

美国发现“无敌细菌” 所有抗生素无效
美国发现“无敌细菌” 所有抗生素无效

大肠杆菌电子显微图。(图片来源:新华/美联)
美国疾病控制和预防中心26日证实,美国发现首例“无敌细菌”病例,对现阶段全部抗生素都具有耐药性。
对现阶段全部抗生素具备耐药性
美国微生物学会刊物《抗微生物制剂与化学疗法》的一篇报告说,美国一名49岁女性4月26日因尿路感染症状就医,被发现感染这种细菌。报告没有说明这名女患者现在情况如何。
中国和英国研究人员去年在英国《柳叶刀·传染病》杂志上首次报告,在中国的畜禽和人类身上发现携带MCR—1基因的细菌。
这种基因使得细菌对现阶段全部抗生素具备耐药性,包括被视为“最后一道防线”的粘菌素。

抗生素。
粘菌素早在1959年就开始使用,然而由于对肾脏有损害,于上世纪七八十年代停止用于人体,但是在畜禽饲养业中仍广泛使用。
不过,由于细菌对抗生素的耐药性越来越强,这名“老将”又披挂上阵。“它是一种老抗生素,但它是我们所剩唯一能对抗‘噩梦细菌’的抗生素。”美国疾病控制和预防中心主任托马斯·弗里登26日说,“我们正面临进入后抗生素时代的危险。”
他当天在美国全国记者协会午餐会上说:“对耐药性的情况研究越多,我们越忧虑。对一些患者而言,已经无药可医。我们必须紧急行动起来,否则抗生素将走到尽头。”
美国发现“无敌细菌”
可能会迅速传播
报告说,这名美国女患者住在宾夕法尼亚州,病情被发现前5个月内没有去过其他国家。弗里登说,她的病不大可能感染自其他国家。
美国哈佛医学院微生物学家盖尔·卡斯尔警告:“这是危险情况。我们可以推测,它可能会迅速传播。如果防护不当,甚至可能在医院传播。”
另外,强耐药细菌从动物传播至人,也是主要忧患。
卡斯尔说,必须进一步弄清这名病患的感染源和这种细菌在美国及全球的存在情况,然后才能知道它的传播速度。
她建议,为避免感染,公众应该认真洗手,水果和蔬菜应彻底洗净后食用,应该用正确方法处理其他食材。

滥用抗生素是主因
滥用抗生素是导致细菌耐药性越来越强的主要原因。
在美国,每年至少2.3万名病患因抗生素无效死亡。而且,抗生素在禽畜身上也遭滥用,从另一个方面降低了它们的抗病效果。
世界卫生组织总干事陈冯富珍2月在欧洲联盟一次耐药性问题会议上说,如果粘菌素失效,“我们就失去了对抗一系列严重感染的最后药品”。
“这是一场危机,全球危机。”她警告。
美国疾病控制和预防中心主任弗里登说,必须研究新的抗生素,同时加强对现有药物的应用监管。“我们需要做非常全面的工作,以保护抗生素,从而我们能用它们,我们的后代能用它们。”
路透社报道,许多药品生产商不愿意投资研发新抗生素,宁愿把资金用于价格高昂、利润更丰厚的抗癌药物和疑难病药物研发。
今年1月,十多家大药企联合发表宣言,呼吁政府采取新的激励措施,推动药企研发新药以对抗具有强耐药性的“超级细菌”。
文/惠晓霜(新华社专特稿)

科学家复活冰冻水熊虫

据报道,科学家们成功地将一个卵子和一个活体动物复活。两星期后,这个活体动物开始移动并吃食。这个卵子又产了另外19个卵子,其中孵化成功的有14个卵子。研究者称,这些孵化出的新生幼仔并无缺陷和异常。

1983年,科学家们在南极洲的苔藓植物中发现这些缓步生物,之后它们一直被隔离并保存在零下20℃的环境下,2014年5月科学家们将其成功解冻。虽然早先也有研究人员成功复活了冰冻9年的缓步动物,但日本科学家的这次研究第一次成功将冰冻了30年的缓步动物复活。

据悉,这种被称作“水熊虫”或“缓步动物”的生物体积极小,是一种生活在水里的极端微生物,长度不足1毫米。它们生命力极强,能够在极端恶劣的条件下存活并长时间放慢或停止自己的新陈代谢活动。

该研究作者在论文中写道:“当前的研究极大地延长了缓步动物已知的存活时间。未来还会有运用定量分析的详细研究,在一系列受控条件下对它们进行复制,这将提高人们对动物长期保护和存活机制以及条件的理解。”

水熊也称水熊虫(Water Bear),是对缓步动物门生物的俗称,有记录的约有900余种,其中许多种是世界性分布的。水熊体型极小,必须用显微镜才能看清,身体表层覆盖着一层水膜,用于避免身体干燥,同时可呼吸水膜中的氧气。主要生活在淡水的沉渣、潮湿土壤以及苔藓植物的水膜中,少数种类生活在海水的潮间带,靠尖锐的吸针吸食动植物细胞里的汁液为生。最大的特点是它从卵里生出来就已成年,无童年时期,身体里细胞的数量终生都不再改变。

水熊是地球上生命力最强的生物,可以在没有防护措施的条件下在外太空生存,在喜马拉雅山脉(6000m 以上)和深海(4000m 以下)都能生存。

洞穴狮子的尸体只有家猫大小,冻土将它们的外形完整的保留下来,但它们有着1.2万年甚至更长的历史。(网页截图)

西伯利亚冰冻万年狮子尸体展出
今年夏季,考古学家在西伯利亚雅库特冻土带中发现两具已冻结上万年的洞穴狮子尸体。当地考古学家称,这是迄今为止在该地区发现的保存最为完整的洞穴狮子尸体。

17日,这两只洞穴狮子的尸体在雅库特被展出。它们只有家猫大小,冻土将它们的外形完整的保留下来,但它们有着1.2万年甚至更长的历史。

专家称,这两只洞穴狮子都是不足满月的幼崽,牙齿还未长出,1万余年前曾生活在今天的雅库特境内。它们的软组织也得到很好的保存,所以它们是可以被克隆的。而克隆工作两三年之后才能有结果。

专家认为,此次发现能够回答有关洞穴狮子起源的诸多问题,因为此前从未发现过完整的洞穴狮子尸体。来自日本、韩国和美国的专家都参与了相关研究。

这两具狮子尸体因被深埋在地下而得以完好保存。微生物学家从尸体上分离出4类微生物菌种,已交由莫斯科州普希诺市科研中心进行研究。

-
- 贾浅浅的《日记独白》及其它诗真有这么差吗?我看未必如此
-
2025-07-02 03:10:50
-
- 2次被捕入狱,全网炫富一晚40万的郭美美,如今又傍上富二代?
-
2025-07-02 03:08:35
-
- 亚泰集团创始人辞职,任职董事长达26年!公司或连亏4年,近年谋求出售资产回
-
2025-07-02 03:06:20
-
- 掀桌子时用到的底牌:中国现役有多少核武器?打起来够用吗
-
2025-07-02 03:04:06
-
- 美国发出全球通缉令,逮捕中国芯片科学家陈正坤,现在怎么样了?
-
2025-07-02 03:01:51
-
- 李宁换回31年前的logo,再次验证“老字号是最成功的新品牌”?
-
2025-07-02 02:59:36
-
- 典型经验材料的写作之道
-
2025-07-02 02:57:21
-
- 错的不是我!电竞游戏玩家输了常用的一些借口
-
2025-07-02 02:55:06
-
- 热播剧《分界线》导演潘军专访:人间正道的分界线每个人都要坚守
-
2025-07-02 02:52:51
-
- 网曝男艺人感染HIV?娱乐圈因患艾滋病去世的10大明星
-
2025-07-02 02:50:36
-
- 印度女神迪莎·帕塔尼:从“印度西施”到国际巨星
-
2025-07-02 02:48:22
-
- 女演员马苏:曾和孔令辉相恋11年,为何现如今却孑然一身?
-
2025-07-02 02:46:07
-
- 63岁陈冲近况曝光,曾让晚导演给全国道歉,如今过得怎样?
-
2025-07-02 02:43:52
-
- 全红婵又又又误入巨人国了?孙颖莎笑得好开心?潘展乐全红婵好萌
-
2025-07-02 02:41:37
-
- 北京:7月1日起医院将建安检制度,二级以上医院设警务室
-
2025-07-02 02:39:22
-
- 云南白药创始人:拒绝交出配方被迫害,死前亲手毁掉防伪印章
-
2025-07-02 02:37:07
-
- 好尴尬!叶珂打假整容前原生脸,网友公开新证据,前夫点赞被扒
-
2025-07-02 02:34:53
-
- 华为群英榜:“华为女皇”孙亚芳
-
2025-07-01 18:16:56
-
- 地震进入“活跃期”?天津地震专家分析长宁地震 提示公众:天津近期出现破坏性
-
2025-07-01 18:14:42
-
- 任昌丁九部高分电影推荐,色即是空只能排第三名
-
2025-07-01 18:12:27



苍月奥特曼:来自宇宙的战士
字节跳动市值多少亿(字节跳动高估值的原因)